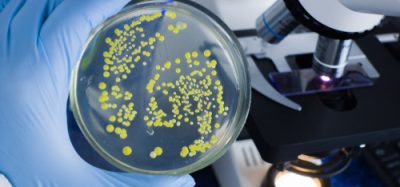
A scientist's gloved hand holding a petri dish showing microbial cultures in a food safety laboratory

Coca-Cola recalls more than 70,000 cans over metal contamination concerns
Posted: 24 October 2025 | Ben Cornwell | No comments yet
Coca-Cola has recalled three soft drink brands from Texas shelves after discovering cans may contain metal fragments.


Credit: Toomko / Shutterstock.com
Coca-Cola has recalled thousands of cans of its flagship soft drink brands in Texas after discovering some may pose a risk of metal contamination, which could cause injury if consumed.
Nothing is more important to us than providing safe, high-quality products to our consumers.”
According to a notice issued by the US Food and Drug Administration (FDA) on 20 October, the voluntary recall affects more than 70,000 cans of Coca-Cola, Coca-Cola Zero Sugar and Sprite.
The drinks were produced and distributed in Texas by Coca-Cola Southwest Beverages, LLC, a subsidiary of bottling giant Arca Continental. The recall covers specific areas in Texas, namely McAllen/Rio Grande Valley and San Antonio.
A Coca-Cola spokesperson said the company removed all affected products from store shelves by 10 October “out of an abundance of caution.” They added: “Nothing is more important to us than providing safe, high-quality products to our consumers.”
No injuries have yet been reported.
FDA Class II recall explained
The Texas-based bottler initiated the recall on 3 October, with the FDA later classifying it as a Class II recall.
This designation applies when products “may cause temporary or medically reversible adverse health consequences or where the probability of serious adverse health consequences is remote.”
In contrast, Class I recalls carry a significant risk of serious injury or death, while Class III recalls involve products with unlikely health risks.
Coca-Cola hit by recalls earlier in 2025
This latest recall follows two similar incidents involving Coca-Cola products earlier this year.
In January, Coca-Cola Europacific Partners Belux recalled several beverages in Belgium, Luxembourg and the Netherlands due to elevated chlorate levels in certain batches.
A few months later, the company pulled more than 10,000 cans of Original Coca-Cola from Illinois and Wisconsin after reports of plastic contaminants.
Such incidents underline how product recalls, even when precautionary, can pose significant legal, reputational and brand management challenges for companies.
Affected multipacks
The recall affects more than 4,000 units across multiple pack sizes, each identifiable by precise codes and best-before dates:
- Coca-Cola Zero Sugar 12oz (12 pack) — 49000042559, FEB0226MAA
- Coca-Cola Zero Sugar 12oz (35 pack) — 49000058499, FEB0226MAA
- Coca-Cola 12oz (24 pack) — 49000012781, JUN2926MAA
- Coca-Cola 12oz (35 pack) — 49000058468, JUN2926MAA
- Sprite 12oz (35 pack) — 49000058482, JUN2926MAA
- Sprite 12oz (12 pack) — 49000028928, JUN2926MAA
- Sprite 12oz (12 pack) — 49000028928, JUN3026MAB
What consumers should do
Consumers should not drink the affected cans and should return them to the original store for a refund or replacement. Customers may also contact the company’s Consumer Interaction Center on (800) 438-2653.
Related topics
Beverages, Contaminants, Food Safety, Outbreaks & product recalls, Packaging & Labelling, recalls, retail, Supermarket, The consumer, World Food